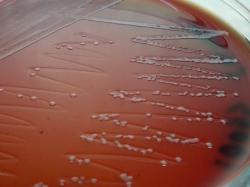

| Pasteurellosis in German Lop rabbit - short communication - DVM Costin Stoica |
A Gram-negative, non-motile coccobacillus was
isolated from the lungs, heart and liver of a dead
German Lop rabbit. Necropsy show pleuritis,
thoracic adhesions with fibrin deposits, purulent
pneumonia, blood collection in trachea, nasal
discharges and spotted liver.
The parasitological examination was negative.
The bacteriological examination found Pasteurella
multocida subsp. septica from heart, lungs and liver
and was negative from kidney and bone marrow.
Morphological and biochemical properties:
After 24h incubation on sheep blood agar, colonies
were 2-3 mm in diameter, white-gray and
non-hemolytic. No growth on MacConkey agar,
Mueller-Hinton agar and Simmons citrate agar.
Weak growth on TSI agar. Aerobic, facultatively
anaerobic.
Using API 20 NE strips (bioMerieux) the strain was
identified as Pasteurella multocida 96%.
Investigation was extended for more biochemical
characters using API 20 E, API Staph, API Strep
strips and MIU multitest medium.
Based on ABIS online software the strain was
identified as Pasteurella multocida subsp. septica
93%.
isolated from the lungs, heart and liver of a dead
German Lop rabbit. Necropsy show pleuritis,
thoracic adhesions with fibrin deposits, purulent
pneumonia, blood collection in trachea, nasal
discharges and spotted liver.
The parasitological examination was negative.
The bacteriological examination found Pasteurella
multocida subsp. septica from heart, lungs and liver
and was negative from kidney and bone marrow.
Morphological and biochemical properties:
After 24h incubation on sheep blood agar, colonies
were 2-3 mm in diameter, white-gray and
non-hemolytic. No growth on MacConkey agar,
Mueller-Hinton agar and Simmons citrate agar.
Weak growth on TSI agar. Aerobic, facultatively
anaerobic.
Using API 20 NE strips (bioMerieux) the strain was
identified as Pasteurella multocida 96%.
Investigation was extended for more biochemical
characters using API 20 E, API Staph, API Strep
strips and MIU multitest medium.
Based on ABIS online software the strain was
identified as Pasteurella multocida subsp. septica
93%.
Positive results were obtained for alkaline phosphatase, catalase, indole production (positive
in MIU medium and weak in API 20 NE), nitrates reduction, leucine aminopeptidase and
oxidase (negative in first 24h and positive later).
Acid was produced from fructose, glucose (positive in API Staph, weak in API 20 E and
negative in API 20 NE), mannose, mannitol, N-acetyl-glucosamine, saccharose and xylose.
in MIU medium and weak in API 20 NE), nitrates reduction, leucine aminopeptidase and
oxidase (negative in first 24h and positive later).
Acid was produced from fructose, glucose (positive in API Staph, weak in API 20 E and
negative in API 20 NE), mannose, mannitol, N-acetyl-glucosamine, saccharose and xylose.
| Antibiogram |
| Encyclopedia |
| Culture media |
| Biochemical tests |
| Stainings |
| Images |
| Movies |
| Articles |
| Identification |
| Software |
(c) Costin Stoica
| R E G N U M PROKARYOTAE |
| Back |
| Lungs fibrin block and pleuritis. |
| Pasteurella multocida subsp. septica colonies on Sheep Blood Agar. |
Pasteurelosis is an enzootic or epizootic disease in rabbits. It is also known as the "rabbit
hemorrhagic septicemia". The disease can produce fever, loss of appetite, dispnea, rhinitis,
pleuritis, bronchopneumonia, necrosis spots on liver, hemorrhagies on nasal mucosa, pleura
and pericardum. Usually ends with death in four to ten days.
hemorrhagic septicemia". The disease can produce fever, loss of appetite, dispnea, rhinitis,
pleuritis, bronchopneumonia, necrosis spots on liver, hemorrhagies on nasal mucosa, pleura
and pericardum. Usually ends with death in four to ten days.
Negative results for arginine dihydrolase, esculin hydrolysis, alpha- and beta-galactosidase, beta-glucuronidase,
gelatin hydrolysis, hippurate hydrolysis, lysine decarboxylase, ornithine decarboxylase, H2S production, ONPG,
pyrolidonil arylamydase, urease and Voges-Proskauer test.
Acid was not produced from L-arabinose, amygdalin, glycogen, inositol, inulin, lactose, maltose, melibiose, methyl
alpha-D-glucopyranoside, raffinose, rhamnose, sorbitol, starch, trehalose, and xylitol. No utilization as sole carbon
source of: arabinose, mannose, mannitol, N-acetyl-glucosamine, maltose, gluconate, caprate, adipate, malate, citrate
and phenyl-acetate.
Strain was sensitive to neomycin, fosfomycin, florfenicol, gentamicin, erytromycin, spectinomycin, furazolidone,
ampicillin, amoxicillin, and resistant to enrofloxacin, colistin sulphate and oxitetracycline.
Because the disease is common among rabbits, a vaccine using this Pasteurella strain it is intended to be produced.
gelatin hydrolysis, hippurate hydrolysis, lysine decarboxylase, ornithine decarboxylase, H2S production, ONPG,
pyrolidonil arylamydase, urease and Voges-Proskauer test.
Acid was not produced from L-arabinose, amygdalin, glycogen, inositol, inulin, lactose, maltose, melibiose, methyl
alpha-D-glucopyranoside, raffinose, rhamnose, sorbitol, starch, trehalose, and xylitol. No utilization as sole carbon
source of: arabinose, mannose, mannitol, N-acetyl-glucosamine, maltose, gluconate, caprate, adipate, malate, citrate
and phenyl-acetate.
Strain was sensitive to neomycin, fosfomycin, florfenicol, gentamicin, erytromycin, spectinomycin, furazolidone,
ampicillin, amoxicillin, and resistant to enrofloxacin, colistin sulphate and oxitetracycline.
Because the disease is common among rabbits, a vaccine using this Pasteurella strain it is intended to be produced.